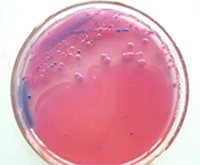
啤酒检测中常见的微生物菌落形态
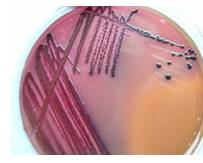
啤酒检测中常见的微生物菌落形态
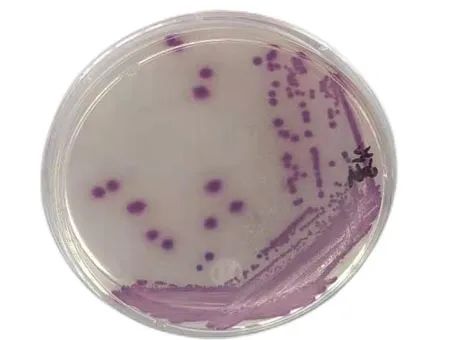
啤酒检测中常见的微生物菌落形态
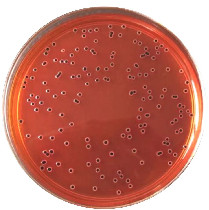
啤酒检测中常见的微生物菌落形态
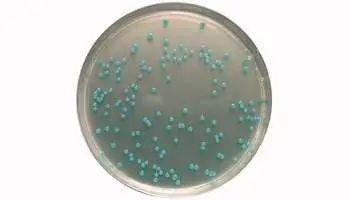
啤酒检测中常见的微生物菌落形态
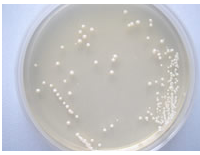
啤酒检测中常见的微生物菌落形态

广东环凯生物科技有限公司品牌商
5 年
手机商铺
- NaN
- 0.20000000000000018
- 1.2000000000000002
- 0.20000000000000018
- 3.2
推荐产品
公司新闻/正文
啤酒检测中常见的微生物菌落形态
458 人阅读发布时间:2023-06-06 13:26
微生物的检测涉及多行业和领域,也是食品领域的重要检测项目之一。菌落总数作为微生物检测的重要指标,我们在实际操作中,却常遇到难以分清微生物菌落等令人苦恼的问题,本期我们针对这些问题给大家进行梳理总结,希望对大家有所帮助,特别是在啤酒进行预包装之前和之后,我们都要做微生物培养和检测(菌落总数;大肠菌群;肠道致病菌(沙门氏菌;李斯特式菌;金葡菌))
细 菌
金葡菌
1. 金葡菌在BP琼脂上典型特征

特征描述: 金葡菌呈圆形,表面光滑、凸起、湿润,直径 2-3mm 。灰黑色至黑色 ,有光泽,常有浅色(非白色)的边缘,周围绕以不透明圈(沉淀),其外常有一清晰带(卵磷脂环)。当用接种针触及菌落时具有黄油样粘稠感。有时可见到不分解脂肪的菌株,除没有不透明圈和清晰带外,其他外观基本相同。从长期贮存的冷冻或脱水食品中分离的菌落,其黑色常较典型菌落浅些,且外观可能较粗糙,质地较干燥。
2. 金葡菌在金葡菌显色培养基上典型特征

特征描述: 典型的金葡菌为灰黑色菌落,其外围有一不透明圈,本培养基用于直接鉴定金葡菌,如果在18-24小时没有出现典型菌落,需再培养18-24小时。有时金葡菌不显灰黑色,但其外围有一不透明圈。
3. 金葡菌在甘露醇高盐琼脂培养基上典型特征

特征描述: 金葡菌显黄色,其外围有一黄色的晕环。
大肠杆菌
1.大肠杆菌在大肠杆菌/大肠菌群显色培养基上典型特征
特征描述: 大肠杆菌典型菌落为蓝色至紫色,大肠菌群为粉红色菌落,其它细菌为无色菌落。
2.大肠杆菌O157菌在O157菌显色培养基上典型特征

特征描述: 典型O157:H7菌显紫色,大肠杆菌和大肠菌群显暗蓝色。
3.大肠杆菌在伊红美蓝琼脂(EMB)上典型特征
特征描述: 大肠杆菌典型菌落为蓝色至紫色,大肠菌群为粉红色菌落,其它细菌为无色菌落。
4.大肠杆菌在月桂基硫酸盐胰蛋白胨肉汤(LST)上典型特征

特征描述: 大肠杆菌分解乳糖产生气体 ,小倒管内收集有气泡。
沙门氏菌
1. 沙门氏菌在沙门氏菌显色培养基上典型特征
特征描述: 典型沙门氏菌显亮红色,大肠杆菌显蓝色绿色,枸橼酸杆菌显紫色,其它细菌显黄色或无色。
2.沙门氏菌在胆硫乳琼脂(DHL琼脂)上典型特征

特征描述: 沙门氏菌在37℃培养22-24小时后,呈无色半透明有黑色中心或几乎全为黑色。有些菌株呈无色半透明。
3.沙门氏菌在亚硫酸铋琼脂(BS琼脂)上典型特征

特征描述: 沙门氏菌在37℃培养24-48小时后,呈棕褐色或灰色至黑色,有时有金属光泽,周围培养基呈棕色或黑色,有些菌株呈灰绿色,周围培养基不变或微变暗。
4.沙门氏菌在XLD琼脂上典型特征
特征描述: 沙门氏菌在35℃培养24-48小时后,呈无色半透明有黑色中心或几乎全为黑色。
5.沙门氏菌在SS琼脂上典型特征

特征描述: 沙门氏菌在 37 ℃ 培养18-24小时后,呈无色透明菌落有黑色中心。
6.沙门氏菌在HE琼脂上典型特征

特征描述: 沙门氏菌在37℃培养18-24时后,沙门氏菌、亚利桑那菌和变形杆菌为蓝绿色至蓝色、有或无黑色中心的菌落。
李斯特氏菌
1.单增李斯特氏菌在李斯特氏菌显色培养基上典型特征
特征描述: 单增李斯特氏菌37℃培养24-28小时,平板上出现蓝色菌落,菌落周围有一不透明环。绵羊李斯特氏菌37 ℃培养48小时,平板上出现蓝色菌落,菌落周围有一不透明环。西尔李斯特氏菌37℃培养24-48小时,平板上出现蓝色菌落,菌落周围没有不透明环。在食品检测中绵羊李斯特氏菌非常少见。
2.李斯特氏菌在PALCAM琼脂上曲型特征

特征描述: 李斯特氏菌在35℃培养24-48小时后,灰绿色菌落。其外围有一黑色环。
蜡样芽胞杆菌
蜡样芽孢杆菌在MYP琼脂上典型特征

特征描述: 蜡样芽孢杆菌显白色 ,其外围有粉红色的晕环。
霉 菌
霉菌在孟加拉红培养基上典型特征

特征描述: 霉菌在孟加拉红培养基上典型特征为灰色菌落,有黑色孢子。
酵 母 菌
1. 酵母菌在孟加拉红培养基上典型特征

特征描述: 酵母菌在孟加拉红培养基上典型特征为红色菌落。
2. 酵母菌在马铃薯葡萄糖琼脂上典型特征
特征描述: 酵母菌在马铃薯葡萄糖琼脂上在28 ℃培养48小时后,呈乳白色菌落,有突起。
最后:随着食品安全越来越重要,啤酒的微生物检测也显得至关重要,好多人经常开玩笑说,啤酒酿坏了,无非是变成醋而已。如果真有这么简单就好了。建议家酿爱好者可以学习一下啤酒检测的相关知识,对于啤酒微生物菌落检测,可以选择使用相对应的显色培养基和选择性培养基。(顺便让大家看一下,前段时间在实验室搞培养基没有加放线-菌酮的对比图)



说明:转载只为分享目的,如有侵权或不愿小编转载发布请联系删除,谢谢!






